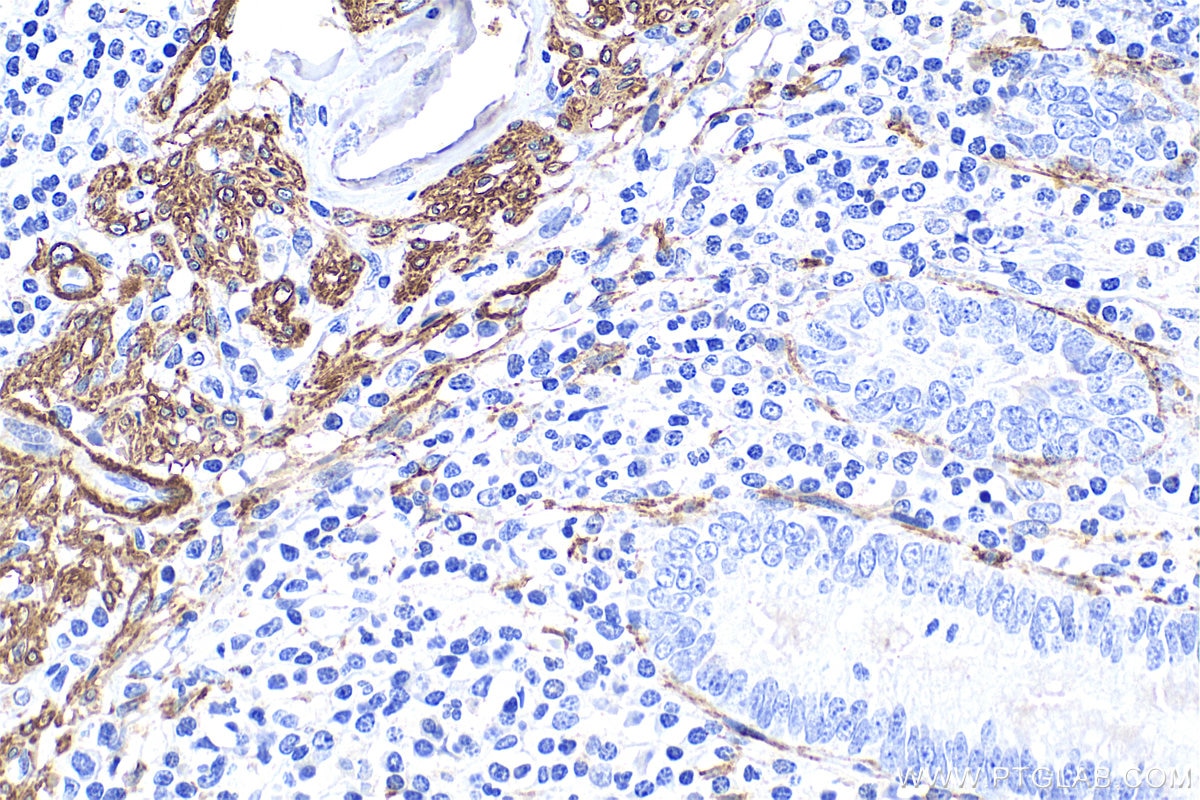
Immunohistochemistry (IHC) staining of human appendicitis tissue using Alpha smooth muscle actin Polyclonal antibody (14395-1-AP)

Tested Applications
| Positive WB detected in | mouse colon tissue, human placenta tissue, A549 cells, HUVEC cells, rat colon tissue, mouse heart tissue, rat heart tissue, mouse liver tissue, mouse kidney tissue |
| Positive IP detected in | mouse liver tissue |
| Positive IHC detected in | human appendicitis tissue, human colon tissue, human heart tissue, human hysteromyoma tissue, human liver cancer tissue, mouse colon tissue, stromal tumor tissue Note: suggested antigen retrieval with TE buffer pH 9.0; (*) Alternatively, antigen retrieval may be performed with citrate buffer pH 6.0 |
| Positive IF-P detected in | mouse heart tissue, mouse small intestine tissue |
| Positive IF-Fro detected in | mouse colon tissue |
| Positive IF/ICC detected in | C2C12 cells, H9C2 cells |
| Positive FC (Intra) detected in | C2C12 cells |
Recommended dilution
| Application | Dilution |
|---|---|
| Western Blot (WB) | WB : 1:2000-1:12000 |
| Immunoprecipitation (IP) | IP : 0.5-4.0 ug for 1.0-3.0 mg of total protein lysate |
| Immunohistochemistry (IHC) | IHC : 1:4000-1:16000 |
| Immunofluorescence (IF)-P | IF-P : 1:1000-1:4000 |
| Immunofluorescence (IF)-FRO | IF-FRO : 1:200-1:800 |
| Immunofluorescence (IF)/ICC | IF/ICC : 1:800-1:3200 |
| Flow Cytometry (FC) (INTRA) | FC (INTRA) : 0.40 ug per 10^6 cells in a 100 µl suspension |
| It is recommended that this reagent should be titrated in each testing system to obtain optimal results. | |
| Sample-dependent, Check data in validation data gallery. | |
Published Applications
| WB | See 989 publications below |
| IHC | See 441 publications below |
| IF | See 612 publications below |
| IP | See 1 publications below |
| CoIP | See 1 publications below |
Product Information
14395-1-AP targets Alpha smooth muscle actin in WB, IHC, IF/ICC, IF-P, IF-Fro, FC (Intra), IP, CoIP, ELISA, competitive binding assay applications and shows reactivity with human, mouse, rat samples.
| Tested Reactivity | human, mouse, rat |
| Cited Reactivity | human, mouse, rat, pig, rabbit, canine, monkey, zebrafish, bovine, sheep |
| Host / Isotype | Rabbit / IgG |
| Class | Polyclonal |
| Type | Antibody |
| Immunogen |
CatNo: Ag5886 Product name: Recombinant human ACTA2 protein Source: e coli.-derived, PGEX-4T Tag: GST Domain: 1-377 aa of BC017554 Sequence: MCEEEDSTALVCDNGSGLCKAGFAGDDAPRAVFPSIVGRPRHQGVMVGMGQKDSYVGDEAQSKRGILTLKYPIEHGIITNWDDMEKIWHHSFYNELRVAPEEHPTLLTEAPLNPKANREKMTQIMFETFNVPAMYVAIQAVLSLYASGRTTGIVLDSGDGVTHNVPIYEGYALPHAIMRLDLAGRDLTDYLMKILTERGYSFVTTAEREIVRDIKEKLCYVALDFENEMATAASSSSLEKSYELPDGQVITIGNERFRCPETLFQPSFIGMESAGIHETTYNSIMKCDIDIRKDLYANNVLSGGTTMYPGIADRMQKEITALAPSTMKIKIIAPPERKYSVWIGGSILASLSTFQQMWISKQEYDEAGPSIVHRKCF Predict reactive species |
| Full Name | actin, alpha 2, smooth muscle, aorta |
| Calculated Molecular Weight | 377 aa, 42 kDa |
| Observed Molecular Weight | 42 kDa |
| GenBank Accession Number | BC017554 |
| Gene Symbol | Alpha smooth muscle actin |
| Gene ID (NCBI) | 59 |
| RRID | AB_2223009 |
| Conjugate | Unconjugated |
| Form | Liquid |
| Purification Method | Antigen affinity purification |
| UNIPROT ID | P62736 |
| Storage Buffer | PBS with 0.02% sodium azide and 50% glycerol, pH 7.3. |
| Storage Conditions | Store at -20°C. Stable for one year after shipment. Aliquoting is unnecessary for -20oC storage. 20ul sizes contain 0.1% BSA. |
Background Information
ACTA2 (also known as α-smooth muscle actin or α-SMA) belongs to the actin family. Actins are highly conserved proteins that are involved in various types of cell motility and are ubiquitously expressed in all eukaryotic cells. ACTA2 is primarily expressed in vascular smooth muscle and anti-ACTA2 is commonly used to marker smooth muscle cells. This antibody may cross-react with other isoforms of actins.
Protocols
| Product Specific Protocols | |
|---|---|
| FC protocol for Alpha smooth muscle actin antibody 14395-1-AP | Download protocol |
| IF protocol for Alpha smooth muscle actin antibody 14395-1-AP | Download protocol |
| IHC protocol for Alpha smooth muscle actin antibody 14395-1-AP | Download protocol |
| IP protocol for Alpha smooth muscle actin antibody 14395-1-AP | Download protocol |
| WB protocol for Alpha smooth muscle actin antibody 14395-1-AP | Download protocol |
| Standard Protocols | |
|---|---|
| Click here to view our Standard Protocols |
Publications
| Species | Application | Title |
|---|---|---|
Cell Metab Nicotinamide metabolism face-off between macrophages and fibroblasts manipulates the microenvironment in gastric cancer | ||
Cell Metab Augmentation of scleral glycolysis promotes myopia through histone lactylation | ||
Mil Med Res Caveolin-1 is critical for hepatic iron storage capacity in the development of nonalcoholic fatty liver disease | ||
Nat Cell Biol LncGata6 maintains stemness of intestinal stem cells and promotes intestinal tumorigenesis. |
Reviews
The reviews below have been submitted by verified Proteintech customers who received an incentive for providing their feedback.
FH Alessandro (Verified Customer) (02-04-2025) | high specificity and sensitivity, providing reliable and reproducible results
|
FH James (Verified Customer) (09-22-2022) | Used by IF. Very well antibody.
![]() |
FH Wu (Verified Customer) (09-08-2022) | Used by IF. Really good signal
![]() |
FH Emma (Verified Customer) (11-29-2021) | Used by IF on FFPE prostate tissue. Tris-EDTA pH 9.0 antigen retrieval.
![]() |
FH Ryan (Verified Customer) (02-28-2019) | Tissue was fixed in PFA and antigen retrieval was done in NaCit ph=6.
|